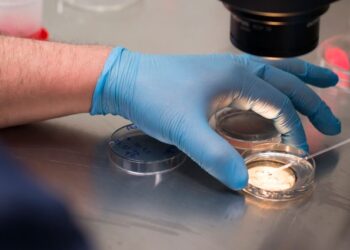

El Hospital Universitario La Luz realiza con éxito una compleja intervención con aterectomía orbital en un paciente con enfermedad coronaria avanzada
La Unidad Integral de Cardiología del Hospital Universitario La Luz de Madrid ha realizado con éxito una intervención pionera con ...